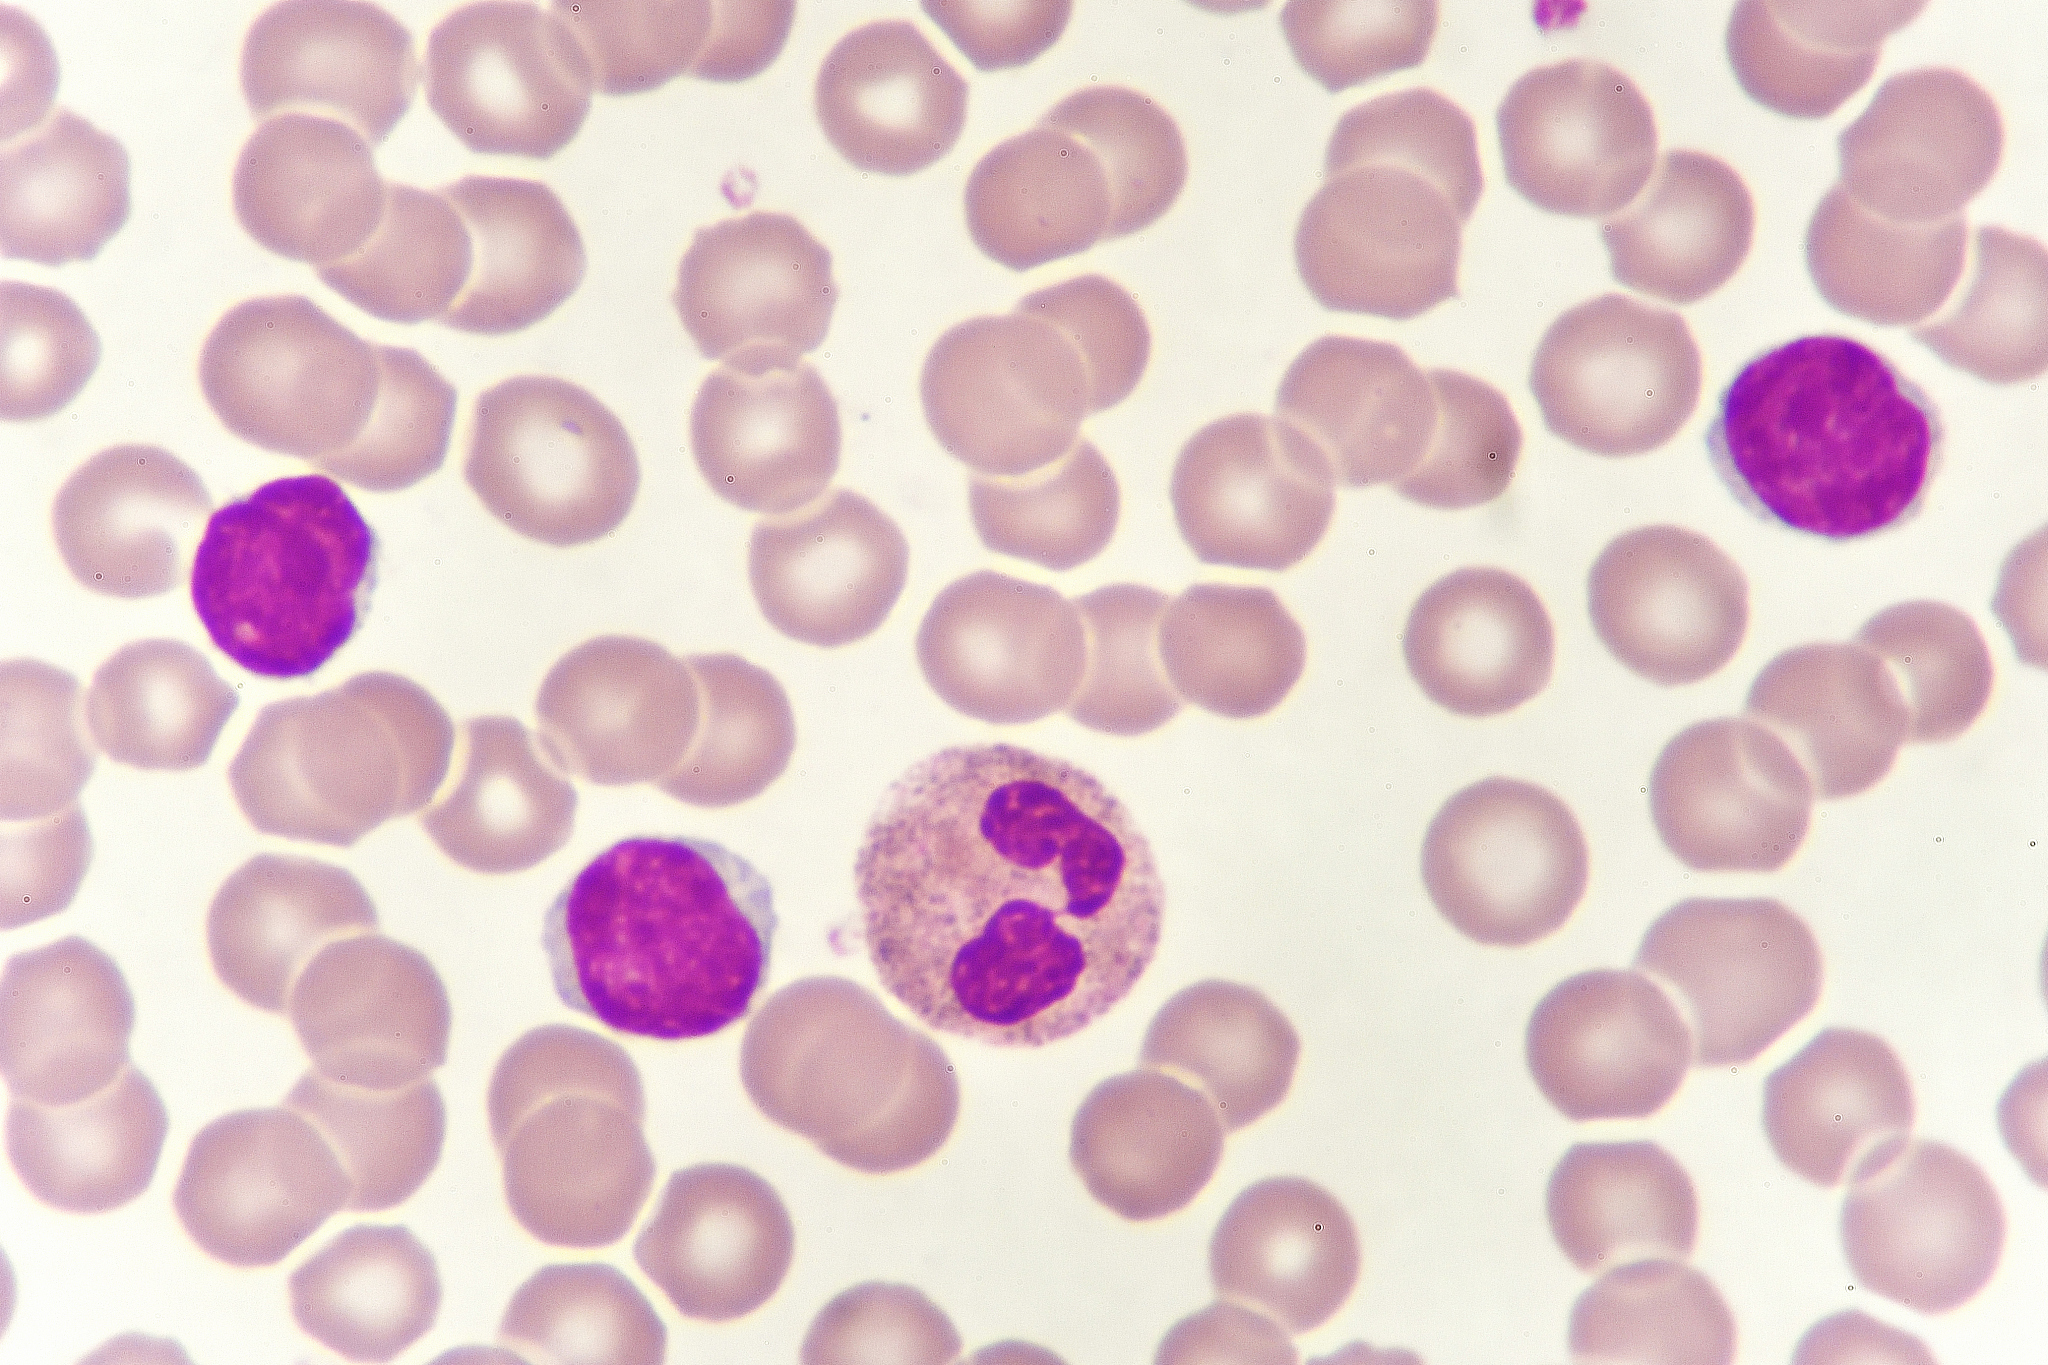
小学四年级《语文》 课程大纲 不少于1500字

小学四年级《语文》 课程大纲 不少于1500字
一、课程目标
小学四年级《语文》课程的目标是培养学生的语文素养,包括语言表达能力、阅读能力、写作能力、文化素养和思维能力等方面。具体目标如下:
-
语言表达能力:培养学生运用正确的语言表达能力,准确、流畅、清晰地表达自己的意思。
-
阅读能力:培养学生阅读理解能力和阅读兴趣,提高他们的阅读速度、深度和广度。
-
写作能力:培养学生的写作能力,使他们能够表达清晰、准确、有逻辑性的观点和思想。
-
文化素养:培养学生对语言、文化、历史等方面的基本素养,增强他们的文化自信心和民族自豪感。
-
思维能力:培养学生的思维能力,包括观察、分析、推理、判断、比较、归纳、概括、发散等方面的能力。
二、教学内容
小学四年级《语文》课程的内容主要包括以下四个方面:
-
语文知识和技能:包括汉字、词语、句子、段落、修辞等方面的知识和技能。
-
阅读:包括课文阅读、课外阅读和文学阅读等方面的阅读能力。
-
写作:包括作文、写日记、写读书笔记等方面的写作能力。
-
文化知识:包括历史、地理、文化等方面的基本知识,以及语言文字的起源、演变和发展等方面的知识。
三、教学方法
小学四年级《语文》课程的教学方法应以学生为中心,注重启发式教学和探究式学习,培养学生的自主学习能力和探究精神。具体方法如下:
-
启发式教学:通过提出问题、展示事例、引导思考等方式,激发学生的学习兴趣和求知欲。
-
探究式学习:通过小组合作、自主探究等方式,培养学生的探究精神和自主学习能力。
-
互动式教学:通过课堂讨论、思维导图、角色扮演等方式,促进学生之间的互动和交流,提高学生的表达能力。
-
多媒体教学:通过图片、音频、视频等多种媒体形式,丰富教学内容,提高学生的学习效果。
四、教学重点和难点
小学四年级《语文》课程的教学重点和难点主要包括以下几个方面:
-
词语和句子的理解和运用:学生需要掌握一定的词语和句子的运用能力,懂得如何正确理解和应用它们。
-
阅读理解能力的提高:学生需要提高阅读理解能力,通过阅读能够获取信息和知识,激发阅读兴趣。
-
写作能力的培养:学生需要掌握一定的写作技巧,能够清晰、准确地表达自己的思想和观点。
-
文化素养的培养:学生需要了解一定的历史、地理、文化等方面的知识,增强文化自信心和民族自豪感。
五、教学评价
小学四年级《语文》课程的教学评价应该以学生为主体,注重综合评价和个性化评价,具体方法如下:
-
综合评价:通过考试、作业、课堂表现等方式,对学生的知识和能力进行综合评价。
-
个性化评价:通过个人作业、小组合作、口头表达等方式,对学生的个性化能力和特长进行评价。
-
自我评价:引导学生进行自我评价,帮助他们发现自己的优势和不足,激励他们自我改进。
-
相互评价:引导学生进行相互评价,培养他们的合作精神和评价能力,促进彼此之间的学习和进步。
六、教学资源
小学四年级《语文》课程的教学资源包括以下几个方面:
-
教材:教师需要充分利用教材,合理安排教学内容和教学进度。
-
多媒体教学:教师可以利用多媒体设备,丰富课堂内容,提高学生的学习效果。
-
图书馆和网络资源:学校图书馆和网络资源是非常重要的教学资源,可以帮助学生深入了解文化知识和阅读材料。
-
教育游戏:教育游戏可以帮助学生轻松愉悦地学习语文知识和技能,提高学生的兴趣和积极性。
七、教学建议
小学四年级《语文》课程的教学建议如下:
-
积极创造良好的教育环境,营造轻松愉悦的学习氛围。
-
注重学生的兴趣和需求,充分发挥学生的主动性和创造性。
-
合理利用教学资源,充分发挥多媒体教学的优势,丰富教学内容。
-
注重学生的个性化和差异化,采用个性化教学策略,帮助学生充分发挥自己的特长和潜力。
-
加强教学评价,通过多种方式对学生进行评价,帮助他们充分发挥自己的优势和潜力,不断提高自己的语文素养。
原文地址: http://www.cveoy.top/t/topic/yQb 著作权归作者所有。请勿转载和采集!